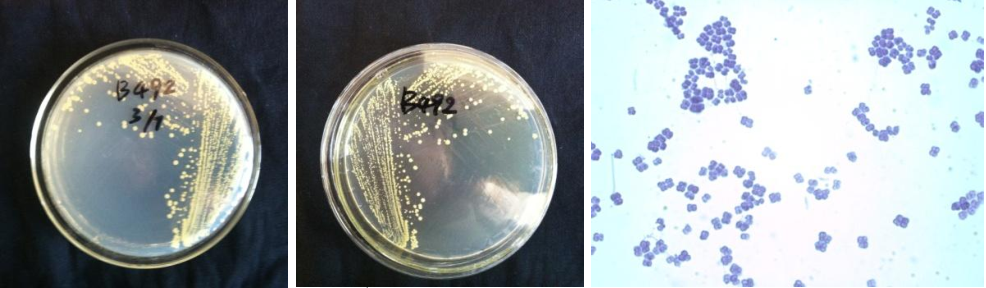

Loading...
| StrainNO | B492 |
| Classification | Micrococcus |
| 16s rDNA sequence | CCCTGATGCTCTTGTTACGACTTAGTCCCAATCGCTGGTCCCACCTTCGACGGCTCCCTCCACAAGGGTTAGGCCACCGG CTTCGGGTGTTACCGACTTTCGTGACTTGACGGGCGGTGTGTACAAGGCCCGGGAACGTATTCACCGCAGCGTTGCTGAT CTGCGATTACTAGCGACTCCGACTTCATGGGGTCGAGTTGCAGACCCCAATCCGAACTGAGACCGGCTTTTTGGGATTAG CTCCACCTCACAGTATCGCAACCCATTGTACCGGCCATTGTAGCATGCGTGAAGCCCAAGACATAAGGGGCATGATGATT TGACGTCGTCCCCACCTTCCTCCGAGTTGACCCCGGCAGTCTCCCATGAGTCCCCACCCGAAGTGCTGGCAACATGGAAC GAGGGTTGCGCTCGTTGCGGGACTTAACCCAACATCTCACGACACGAGCTGACGACAACCATGCACCACCTGTGAACCCG CCCCAAAGGGGAAACCGTATCTCTACGGCGATCGAGAACATGTCAAGCCTTGGTAAGGTTCTTCGCGTTGCATCGAATTA ATCCGCATGCTCCGCCGCTTGTGCGGGCCCCCGTCAATTCCTTTGAGTTTTAGCCTTGCGGCCGTACTCCCCAGGCGGGG CACTTAATGCGTTAGCTGCGGCGCGGAAAACGTGGAATGTTCCCCACACCTAGTGCCCAACGTTTACGGCATGGACTACC AGGGTATCTAATCCTGTTCGCTCCCCATGCTTTCGCTCCTCAGCGTCAGTTACAGCCCAGAGACCTGCCTTCGCCATCGG TGTTCCTCCTGATATCTGCGCATTCCACCGCTACACCAGGAATTCCAGTCTCCCTACTGCACTCTAGTCTGCCCGTACCC ACCGCAGATCCGGGTTAAGCCCCGGGACTTTCACGACAGACGCGACAAACCGCCTACGAGCTCTTTACGCCCATATTCCG GATACGCCTCGCACCCTACGTATTACCGCGCTGCTGCACGTAGTAGCGTGCTTCTTCTGCAGTACGGTCACTTTCGCTCT CCCTACTGAAGAGTTTACACCCGAGCGTCATCCTCACGCGGGTCCTGCATCAGCTTCGCCCATTGGCAATCCAATGTTGC TTCGGTAGGACTGACGTTCTCTGTCATTGACGTACATTCAAGCGTTACCGGTGTGTCGCCTTGTGTGGAACT |
| Strain Morphology Photos | |
| Morphological Description | The morphology of strain:spherical;no spore |